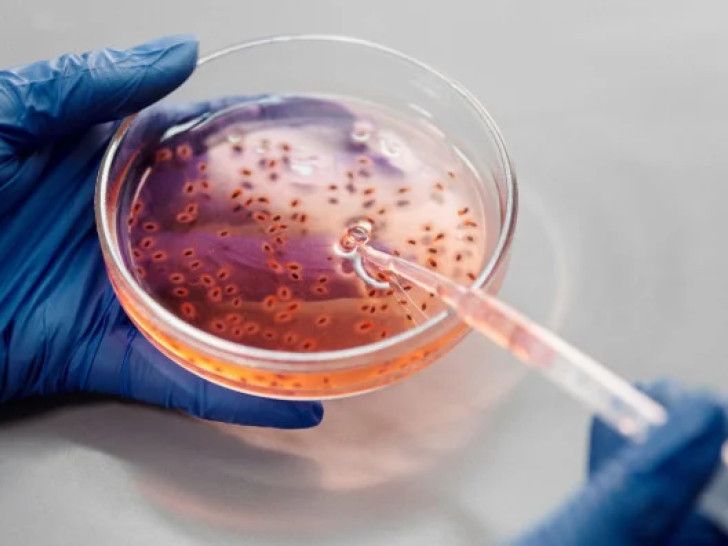

Удружење пољопривредника ФБиХ оптужило је власт у Кантона Сарајево да је због њиховог немара бруцелоза почела прелазити на људе на подручју општине Вогошћа.
Из Удружења тврде да је систем толико заказао да власти нису у стању већ 20 дана да ријеше проблем бруцелозе на подручју ове општине.
Удружења пољопривредника траже од надлежних у Кантона Сарајево хитну реакцију и уклањање заражене стоке док није дошло до још веће катастрофе, наводи се у саопштењу.
Општински штаб цивилне заштите Вогошћа донио је данас закључак да се прогласи стање природне несреће на подручју Кантона Сарајево и општине због погоршане епидемиолошке ситуације и појаве заразне болести – бруцелозе.
Коментари 6
-

Šujo 04.06.2025. 11:25
Bez brige. Nema ođe ljudi. -

Realista 03.06.2025. 20:01
samo napalmom tretirati fekalistan!!!!! -

Skijaš 03.06.2025. 18:11
Šuti kliconošo iz 23 postotnog fekalistana. -

Mirso 03.06.2025. 14:49
I tebi je Rašo i Slobo obećao kokardu od Knina do Prištine pa ste dobili ono što visi između nogu -

Skijaš 03.06.2025. 14:03
Obećao Alija da će jesti zlatnim kašikama ali izgleda da nije rekao ništa za sapun. -

Ђуро 03.06.2025. 09:44
Болесна говеда у федерацији БиХ.
Повезане вијести